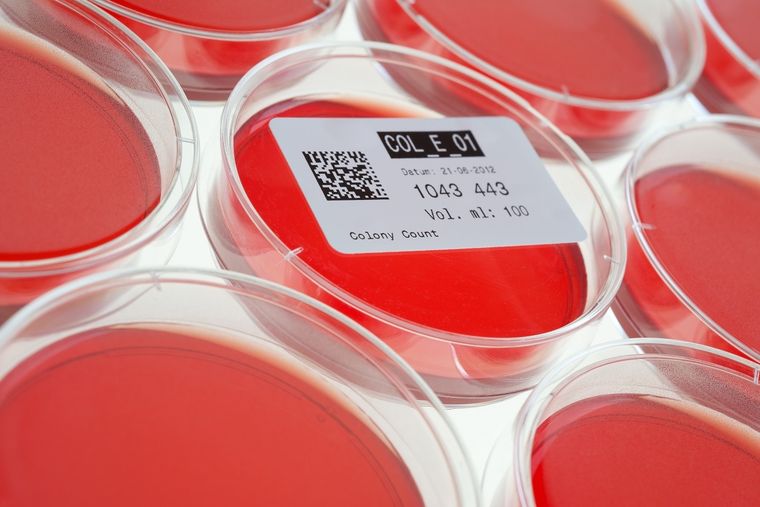
shutterstock Foto: shutterstock

Importante avance en la terapia contra el síndrome urémico hemolítico
Investigadores de Conicet lograron inhibir en estudios in vitro una molécula que favorecería el ingreso al torrente sanguíneo de la toxina liberada por la bacteria Escherichia coli, lo que produce el desarrollo del síndrome urémico hemolítico(SUH), una grave enfermedad que afecta principalmente a chicos y chicas menores de cinco años y puede conducirlos a requerir diálisis, un trasplante de riñón o incluso a la muerte.
"Nuestro estudio abre oportunidades para investigar nuevas estrategias terapéuticas cuyo fin sea evitar la progresión de la infección de Escherichia coli hacia el SUH", indicó Analía Trevani, líder del trabajo publicado recientemente en la revista PLoS Pathogens, investigadora del Conicet y jefa del Laboratorio de Inmunidad Innata del Instituto de Medicina Experimental (IMEX, Conicet-Anm) en un comunicado.
Para esta infección los antibióticos están contraindicados, y si bien existen desarrollos de vacunas y tratamientos específicos, aún no hay ninguno aprobado para su uso en humanos.
La bacteria Escherichia coli puede transmitirse por la ingesta de carne insuficientemente cocida (especialmente picada), frutas o verduras, leche sin pasteurizar e incluso agua.
Al ser ingerida la bacteria accede al intestino, donde libera una toxina potente, llamada Shiga; aunque en la mayoría de los casos la infección se resuelve espontáneamente, en otros, la acción de la toxina puede causar diarrea con sangre o promover una inflamación intestinal y pasar al torrente sanguíneo y de esa forma dañar otros órganos ocasionando el SUH.
En el trabajo, las y los investigadores descubrieron que un tipo de glóbulo blanco, llamado neutrófilo, libera una señal inflamatoria llamada interleuquina 1 beta (IL-1ß) en respuesta a la bacteria.
"Pensamos que es posible que esta molécula promueva la inflamación intestinal y así ayude a que ingrese mayor cantidad de la toxina Shiga al torrente sanguíneo", explicó por su parte Irene Keitelman, también autora del trabajo, becaria posdoctoral de la Agencia Nacional de Promoción de la Investigación, el Desarrollo Tecnológico y la Innovación (Agencia I+D+i) e integrante del laboratorio de Trevani.
En un siguiente paso, el equipo de investigación identificó ciertos inhibidores farmacológicos que fueron capaces de bloquear mecanismos moleculares específicos del neutrófilo involucrados en la liberación de IL-1ß: "De esta forma pudimos disminuir la secreción de IL-1ß en respuesta a la bacteria", explicó Florencia Sabbione, primera autora del estudio e investigadora del Conicet en el grupo de Trevani.
Y agregó: "Además, comprobamos que con este tratamiento el neutrófilo seguía siendo capaz de desarrollar una de sus funciones esenciales que es matar a la bacteria".
Los siguientes pasos de esta investigación serán evaluar inhibidores de la secreción de IL-1ß como tratamiento en un modelo animal de SUH.
"Así podremos determinar si limitando la inflamación causada por los neutrófilos a través de la liberación de IL-1ß se puede evitar la progresión de la infección a la enfermedad grave", afirmó Trevani.
Y continuó: "De tener buenos resultados en los estudios preclínicos a realizar, en el futuro, como en todo proceso de investigación clínica, el siguiente paso sería la realización de ensayos que demuestren la seguridad y eficacia del tratamiento".
El SUH es una enfermedad endémica de Argentina y con una alta incidencia en comparación con el resto del mundo, "su estudio no despierta gran interés en los países con mayores presupuestos para investigación. Por eso resulta relevante que países como el nuestro inviertan en este tipo de investigaciones para resolver problemas de salud de interés local", afirmó Sabbione.
Finalmente, Trevani destacó que "este tipo de trabajos son el fruto de muchos años de investigaciones básicas realizadas para entender los mecanismos que constituyen la base de procesos biológicos. Con ese conocimiento es que luego se pueden desarrollar investigaciones aplicadas para definir nuevas estrategias de intervención farmacológica para tratar enfermedades".
Te puede interesar
WhatsApp prepara una nueva función para ocultar chats: los cambios





